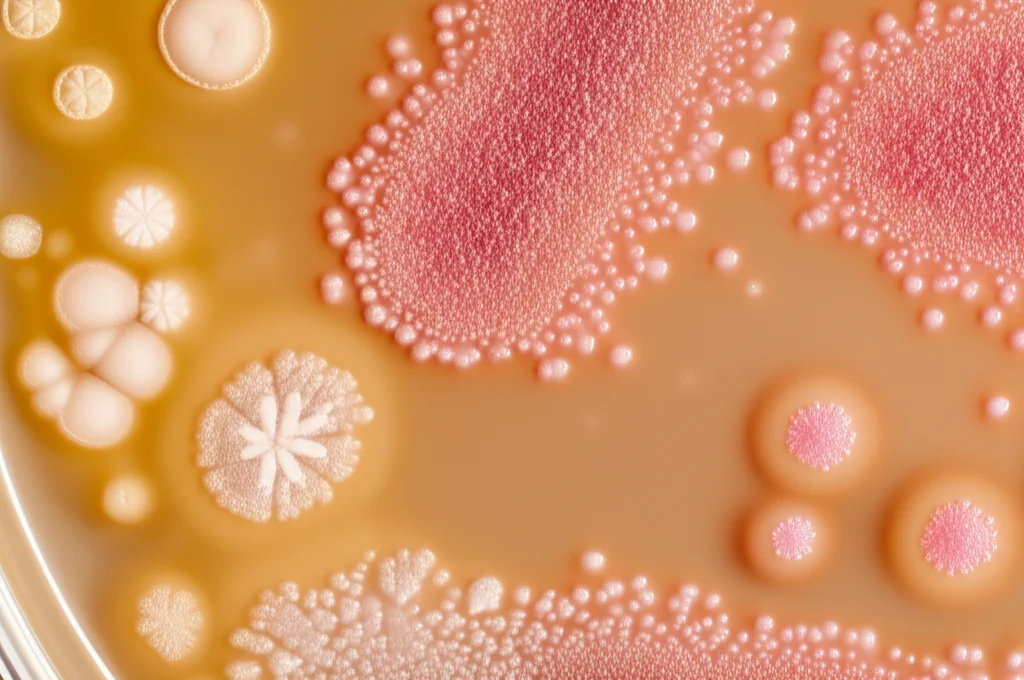
Microfotografia realistica di diverse colonie di lievito su una piastra di Petri con terreno CHROMagar. Si vedono colonie bianche (Candida parapsilosis), beige (altre Candida/Meyerozyma) e rosa/arancio (Rhodotorula). Obiettivo macro 100mm, illuminazione da laboratorio brillante e uniforme, alta definizione, dettagli nitidi delle texture delle colonie.

Lieviti Pericolosi Nascosti nelle Lagune di Rio: Un Allarme dalla Scienza
Ciao a tutti! Oggi voglio portarvi con me in un viaggio affascinante, ma anche un po’ preoccupante, nelle splendide lagune costiere di Rio de Janeiro, in Brasile. Immaginate questi specchi d’acqua, ecosistemi ricchi di vita, importanti per la pesca locale e la biodiversità. Ma cosa si nasconde sotto la superficie, specialmente quando l’impatto umano si fa sentire pesantemente? È proprio quello che abbiamo cercato di scoprire.
Un Mondo Invisibile Sotto Esame
Vedete, quando pensiamo all’inquinamento acquatico, spesso ci vengono in mente batteri come l’E. coli, indicatori classici di contaminazione fecale. Ma c’è un intero regno di microrganismi che viene spesso trascurato: i funghi, e in particolare i lieviti. Questi organismi fanno naturalmente parte della microflora acquatica, ma la loro diversità e distribuzione, soprattutto in acque inquinate, sono ancora poco conosciute.
Il nostro studio si è concentrato proprio su questo: andare a caccia di lieviti potenzialmente patogeni nelle acque superficiali di due importanti sistemi lagunari di Rio, Jacarepaguá (JLS) e Piratininga (PLS). Perché è importante? Beh, pensate al concetto di “One Health”: la salute umana, quella animale e quella ambientale sono indissolubilmente legate. Un ambiente acquatico malato può diventare un serbatoio di microrganismi pericolosi anche per noi. E con l’aumento delle temperature globali, c’è il timore che alcuni funghi possano adattarsi meglio a temperature più alte, aumentando potenzialmente la loro capacità di infettare gli esseri umani.
Due Lagune a Confronto: Storie Diverse di Impatto Umano
Abbiamo scelto specificamente le lagune di Jacarepaguá e Piratininga perché, pur essendo entrambe ecologicamente e socialmente rilevanti (pensate alla pesca di sussistenza!), rappresentano due scenari diversi in termini di gestione ambientale e impatto antropico.
Il sistema lagunare di Jacarepaguá (JLS) è tristemente noto per essere altamente degradato. Situato nella zona ovest di Rio, riceve enormi quantità di scarichi domestici e industriali non trattati, soprattutto da fiumi considerati tra i più inquinati della città. È un’area che ha visto un’urbanizzazione selvaggia, spesso priva di infrastrutture adeguate come le fognature.
Dall’altra parte, la laguna di Piratininga (PL), nella regione oceanica di Niterói, pur subendo anch’essa la pressione dell’urbanizzazione e degli scarichi abusivi, ha beneficiato negli ultimi anni di investimenti significativi per migliorare la qualità dell’acqua, con interventi come zone umide costruite e potenziamento della rete fognaria.
Questa differenza ci ha permesso di confrontare l’impatto dell’inquinamento e valutare i rischi ecologici in due contesti vicini ma gestiti diversamente.
Cosa Abbiamo Trovato nell’Acqua? (Oltre all’Acqua!)
Abbiamo raccolto campioni d’acqua in diversi punti strategici di entrambe le lagune, misurando parametri classici come pH, ossigeno disciolto, salinità, torbidità e nutrienti (azoto e fosforo). E qui le differenze sono emerse chiaramente.
Jacarepaguá (JLS) ha mostrato segni evidenti di forte stress ambientale:
- Valori di richiesta biochimica di ossigeno (BOD) e richiesta chimica di ossigeno (COD) altissimi, ben oltre le soglie critiche, indicando un carico organico enorme (in parole povere, tanto “sporco”).
- Livelli di azoto totale molto elevati e presenza di fosforo totale superiore ai limiti, confermando un forte arricchimento di nutrienti (eutrofizzazione), tipico degli scarichi fognari.
- Parametri più variabili tra i diversi punti di campionamento.
Piratininga (PL), pur non essendo perfetta (anche qui BOD e COD erano alti), mostrava livelli di azoto totale decisamente inferiori e fosforo non rilevabile, suggerendo un impatto minore o forse gli effetti positivi degli interventi di risanamento. La laguna appariva anche più omogenea nei suoi parametri.

I Protagonisti Invisibili: Lieviti Emergenti e Potenzialmente Pericolosi
Ma veniamo al cuore della nostra ricerca: i lieviti. Utilizzando tecniche di isolamento su terreni specifici (come il CHROMagar®, che colora diversamente le colonie a seconda della specie) e metodi di identificazione avanzati come il MALDI-TOF MS (una specie di “impronta digitale” molecolare super veloce) e il sequenziamento del DNA (la classica analisi genetica), abbiamo isolato e identificato diverse specie di lieviti in entrambe le lagune.
Nel sistema di Jacarepaguá (JLS), più inquinato, abbiamo trovato lieviti nel 67% dei punti campionati. Le specie più frequenti erano:
- Candida parapsilosis (43% degli isolati): Un nome noto negli ospedali, spesso associato a infezioni in neonati prematuri e pazienti critici, ma sempre più segnalato anche in persone immunocompetenti. Trovarlo così abbondante nell’ambiente è un campanello d’allarme.
- Cyberlindnera jadinii (ex Candida utilis) (29%): Comunemente usato nell’industria alimentare, ma capace di causare infezioni gravi (candidemia) in pazienti immunocompromessi.
- Candida catenulata (Syn. Diutina catenulata) (14%): Segnalata raramente in infezioni umane, ma trovata in alimenti (uova) e potenzialmente resistente ad alcuni antifungini.
- Lachancea fermentati (14%): Anch’essa usata in biotecnologia, ma con potenziale patogeno opportunistico.
Nella laguna di Piratininga (PL), abbiamo trovato lieviti nel 60% dei punti. Qui le specie dominanti erano diverse:
- Meyerozyma guilliermondii (ex Candida guilliermondii): Specie opportunista, responsabile di infezioni soprattutto in immunocompromessi, e nota per presentare resistenze agli antifungini.
- Candida parapsilosis (25%): Presente anche qui, confermando la sua diffusione.
- Rhodotorula mucilaginosa (25%): Un lievito “colorato” (produce colonie rosa/arancio), trovato in ambienti estremi e considerato un bioindicatore, ma anche la quarta causa più comune di fungemia dopo le Candida, spesso associata a cateteri e dispositivi medici.
- Wickerhamomyces anomalus (ex Pichia anomala): Trovato spesso nell’uva e nel vino, ma segnalato come causa rara ma grave di fungemia, specialmente nei neonati, e resistente a molti antifungini.
È interessante notare come la maggiore salinità media di Piratininga potrebbe aver influenzato la minore presenza di C. parapsilosis rispetto a Jacarepaguá. Inoltre, il pH più vicino alla neutralità/leggermente basico di Jacarepaguá potrebbe aver favorito una maggiore crescita fungina generale rispetto al pH più alcalino di Piratininga.
Non Solo Lieviti: Batteri Super-Resistenti
Ma non è finita qui. Abbiamo anche cercato batteri, in particolare quelli resistenti agli antibiotici, utilizzando terreni selettivi. E i risultati sono stati altrettanto preoccupanti.
In entrambe le lagune, le specie batteriche più isolate sono state Escherichia coli e Klebsiella pneumoniae, entrambi noti patogeni opportunisti. La cosa allarmante è stato il loro profilo di resistenza:
- In JLS, il 75% dei batteri isolati era resistente a tre o più classi di antibiotici (multiresistenza).
- In PL, la percentuale era del 69.57%.
- Abbiamo calcolato l’indice MAR (Multiple Antibiotic Resistance), che indica il rischio associato all’uso di antibiotici nell’ambiente. Valori superiori a 0.2 sono considerati ad alto rischio. Ebbene, molti dei nostri isolati superavano abbondantemente questa soglia, con picchi fino a 0.81 in JLS e 0.72 in PL!
- Abbiamo trovato batteri resistenti a cefalosporine di terza generazione e persino ai carbapenemi, antibiotici considerati spesso l’ultima linea di difesa.
La presenza massiccia di batteri così resistenti, definiti “critici” dall’Organizzazione Mondiale della Sanità, in queste acque è un segnale fortissimo dell’impatto dell’inquinamento (scarichi ospedalieri, zootecnici, urbani) e della diffusione dell’antibiotico-resistenza nell’ambiente, che può poi tornare a colpire l’uomo.
Il Quadro Generale: Un Ecosistema Sotto Pressione e Rischi Concreti
Cosa ci dice tutto questo? Che le lagune di Rio, soprattutto Jacarepaguá, sono ecosistemi sotto forte pressione antropica. L’inquinamento da scarichi non trattati non solo ne degrada la qualità chimico-fisica, ma crea un ambiente favorevole alla proliferazione di microrganismi potenzialmente pericolosi, sia lieviti che batteri, e spesso resistenti ai farmaci che usiamo per curarci.
La co-occorrenza di lieviti patogeni emergenti e batteri multiresistenti nello stesso ambiente suggerisce che potrebbero condividere nicchie ecologiche simili ed essere soggetti alle stesse pressioni selettive (esposizione ad antibiotici, metalli pesanti presenti nell’inquinamento).
Questo non è solo un problema ecologico, ma un chiaro rischio per la salute pubblica. Pensate ai pescatori che lavorano in queste acque, alle persone che potrebbero entrarci in contatto per attività ricreative, o anche indirettamente, attraverso il consumo di pesce contaminato. L’approccio “One Health” ci ricorda che non possiamo separare la nostra salute da quella dell’ambiente che ci circonda.

Cosa Fare? L’Importanza del Monitoraggio e dell’Intervento
Il nostro studio sottolinea l’urgenza di interventi mirati per mitigare l’inquinamento in entrambe le lagune, ma con particolare priorità per Jacarepaguá. Ma non basta. È fondamentale implementare un monitoraggio a lungo termine che non si limiti ai soliti parametri chimico-fisici o ai batteri fecali, ma includa specificamente la ricerca di questi lieviti patogeni emergenti e dei batteri resistenti.
Identificare precocemente questi “intrusi” negli ecosistemi acquatici può aiutarci a prevenire epidemie, proteggere la biodiversità locale e mitigare i rischi per la salute pubblica, ottimizzando anche le spese sanitarie.
Insomma, la prossima volta che guardate uno specchio d’acqua, soprattutto vicino a zone urbanizzate, ricordate che sotto la superficie potrebbe nascondersi un mondo microscopico complesso e, a volte, pericoloso. Proteggere questi ambienti significa proteggere anche noi stessi.
Fonte: Springer
